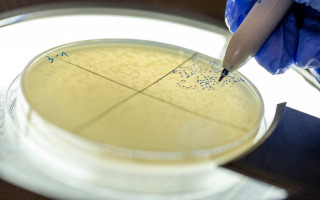
Tiny Viral Switch Offers Hope Against Drug-Resistant Bacteria

Protecting Wildlife from Genetic Collapse with Newly Identified "Early Warning Signals"
A new study reveals that habitat fragmentation can lead to sudden "tipping points" where a species' genetic health unexpectedly collapses after appearing stable for long periods. By merging network theory with population genetics, the research identifies detectable "early warning signals" in genetic data that can alert conservationists to an approaching crisis before it becomes irreversible. These findings provide a practical toolkit for monitoring wildlife populations and protecting the genetic diversity essential for animals to survive a changing environment.